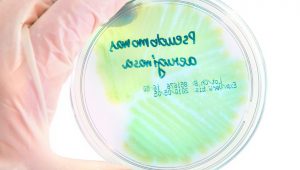
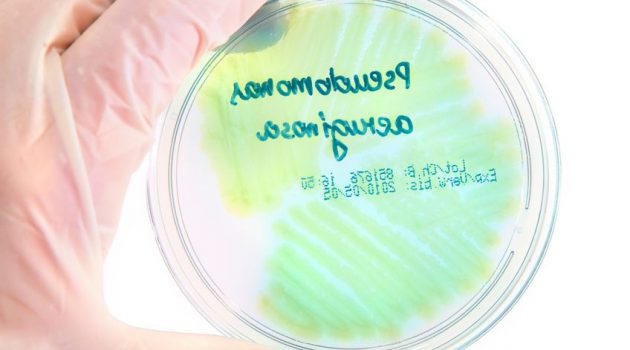

Aktuelles
Aktuelles
Schnelle Hilfe für Patienten mit Depression
Zeitnahe Abklärung und Therapie mit Selektivvertrag zwischen AOK Nordwest und Ärztenetz. Im Norden Deutschlands soll ein Selektivvertrag zu einer schnelleren ambulanten Versorgung für Patienten, die unter Depressionen zu leiden...
Aktuelles
Zu krank zum Arbeiten? Die Krankenkasse bestimmt das nicht!
Eigentlich kaum vorstellbar, doch Krankenkassen drängen ihre Kunden häufig bei einer längeren Erkrankung so schnell wie möglich wieder arbeiten zu gehen. Dabei sind viele der angewandten Methoden verboten. Was dürfen die Kranke...
Aktuelles
Arzt und Patient: Präzise Diagnose durch gute Kommunikation
Wer kennt sie nicht, die Situationen in denen man ein größeres kommunikatives Engagement hätte zeigen können. Beim Thema Gesundheit tritt diese Problematik desöfteren in Erscheinung. Die Körpersprache und die dazugehörigen Äuße...
Aktuelles
Pseudomonas aeruginosa: Zuckerwirkstoff schützt Zellen vor dem Bakterium
Bakterien müssen draussen bleiben: Ein europäisches Team von Forschern hat einen Wirkstoff gegen den Krankenhauskeim Pseudomonas aeruginosa gefunden. Mit Hilfe eines Zuckerwirkstoffs gelang es den Wissenschaftlern, den Zugang z...
Aktuelles
Ärzte verschreiben zu oft Antibiotika
Einer aktuellen Studie zufolge verschreiben Ärzte bei Mandel- Mittelohr- oder Rachenentzündungen in zu häufigen Fällen Antibiotika. Zwar können diese für eine erfolgreiche Behandlung entscheidend sein, allerdings besteht auch d...
Aktuelles
Wenn die Nacht keine Ruhe bringt
Dass ausreichender Schlaf eine gute Basis für ein gesundes Leben ist, dürfte weitläufig bekannt sein. Die Forschung konnte in diesem Bereich vieles nachweisen und liefert immer wieder neue Einblicke in das positive Wirken der N...
Aktuelles
Warnwestenpflicht ab 01. Juli 2014!
An die Warnweste gedacht? Stellen Sie sich diese Frage besser jetzt, als erst in ein paar Tagen. Denn ab dem 01. Juli 2014 wird das Mitführen einer Warnweste im eigenen PKW zur Pflicht in Deutschland und der EU. Laut einer Umfr...
Aktuelles
Gluten, Histamin, Laktose: Viele Nahrungsmittel werden von Deutschen gemieden
Ein Blick in die Regale des Supermarkts verrrät einiges über den Lebensmittelkonsum: Produkte ohne Gluten oder Laktose sind längst keine Seltenheit mehr. Laut einer aktuellen Umfrage sind 23 Prozent der Deutschen von Nahrungsmi...